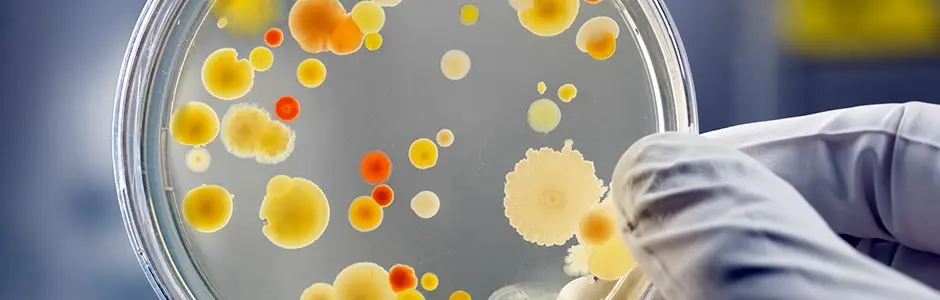
Antibacterial Antibacterial

Berberine Hydrochloride Powder
CAS No: 633-65-8
Specification: 98% Berberine hydrochloride
Appearance: Yellow powder
Test Method: HPLC
Extract Source:100% Natural
Origin:China
Lead time: 1-3 days
Storage: Cool dry place and avoid light
Shelf Life: 2 years
MOQ: 1KG
Sample: Free sample available
Certifications:GMP, ISO9001:2015, ISO22000:2018, HACCP, KOSHER, HALAL
Payment: Multiple terms acceptable like T/T, LC, DA
Advantage: 100,000-level clean production workshop, Non-additive, Non-GMO, radiationless qualified product.
- Fast Delievery
- Quality Assurance
- 24/7 Customer Service
Product Introduction
Berberine hydrochloride Manufacturer and Supplier
Widely applied within traditional Chinese medical practices, berberine hydrochloride exhibits a broad spectrum of pharmacological properties. These include antibacterial, anti-inflammatory, antioxidant, antitumor, and blood-glucose-lowering effects.

Berberine hydrochloride, produced by Healthkintai®, is a key bioactive compound derived from the Coptis Chinensis plant (also known as Chinese Goldthread). Chemically classified as an oxalate alkaloid with the systematic name *8,9-dihydro-5-methoxy-2,3-methylenedioxy-6H-benzofuro[3,2-c][1]benzazocin-6-one hydrochloride*, it has long been utilized in traditional Chinese medicine. This compound is especially recognized for its efficacy in treating digestive disorders and regulating blood glucose.If you need 97%98%berberine hydrochloride,please feel free to contact us at health@kintaibio.com.

KINTAI Berberine hydrochloride COA

KINTAI Berberine hydrochloride Spcifications
|
Property Category |
Description |
|
Chemical Name |
5,6-Dihydro-9,10-dimethoxybenzo[g]-1,3-benzodioxolo[5,6-a]quinolizinium chloride |
|
Spcifications |
97%&98% Berberine hydrochloride |
|
CAS Number |
633-65-8 |
|
Molecular Formula |
C₂₀H₁₈ClNO₄ |
|
Molecular Weight |
371.81 g/mol |
|
Appearance |
Yellow crystalline powder |
|
Melting Point |
Decomposes at approximately 200 °C |
|
Solubility |
Water: Slightly soluble |
|
Optical Activity |
Optically inactive (It is a quaternary ammonium salt) |
|
Chemical Structure |
A natural quaternary ammonium salt from the protoberberine group of benzylisoquinoline alkaloids. |
|
Stability |
Stable under recommended storage conditions. Incompatible with strong oxidizing agents. |
|
pKa |
pKa ≈ 2.47 (for the conjugate acid of the tertiary amine precursor) |
|
UV-Vis Spectroscopy |
λ_max (in ethanol): ~ 345 nm and ~ 425 nm, contributing to its intense yellow color. |
Interested?We'd love to send you a free sample! CONTACT US>>>
Chemical&Physical Properties

| CAS Number | 633-65-8 | Density | 1.654 g/cm3 |
| Molecular Formula | C20H18ClNO4 | Molecular Weight | 371.81 |
| Melting Point | 204-206 ℃ (dec.) | Boiling Point | N/A |
| Solubleness | Soluble in methanol | Test Method | HPLC |
Berberine Hydrochloride Dosage
|
Category |
Application / Indication |
Typical Dosage Range & Notes |
|
Traditional & Primary Use |
Bacterial Gastroenteritis & Diarrhea |
Adults: 300-500 mg, taken 3 times a day. The course of treatment is usually 3-7 days. It is often taken right before or after a meal. |
|
Modern & Supplemental Uses
|
Blood Sugar Management (Type 2 Diabetes/Pre-diabetes) |
500 mg, taken 2-3 times daily with meals (totaling 1000-1500 mg/day). Crucial: This must be done under medical supervision as it can interact with diabetes medication and cause hypoglycemia. |
|
Blood Lipid Management (High Cholesterol/Triglycerides) |
500 mg, taken 2 times daily with meals (totaling 1000 mg/day). Often used as an adjunct to diet and lifestyle changes. |
|
|
Polycystic Ovary Syndrome (PCOS) |
500 mg, taken 2-3 times daily with meals (totaling 1000-1500 mg/day). Used to improve insulin sensitivity and metabolic parameters. |
|
|
General Considerations
|
Form |
Commonly available in tablets or capsules. |
|
Administration |
Taken with or shortly after meals to improve tolerance and leverage its post-meal glycemic effect. |
|
|
Safety |
Generally well-tolerated. Common side effects include constipation, bloating, or stomach upset. Contraindicated in pregnancy, lactation, and in individuals with G6PD deficiency (due to risk of hemolysis). |
|
|
Important Note |
Disclaimer: This information is for educational purposes only. Always consult a healthcare professional before starting any new supplement or medication to determine the appropriate dosage for your specific health condition and to avoid potential drug interactions. |
Berberine hydrochloride Benefits
Antibacterial Action: A Multifaceted Defense Against Pathogens
- Coptis root extract exhibits a robust and broad-spectrum antibacterial activity that extends beyond basic inhibition, making it a cornerstone in combating infectious diseases. Its potency is particularly pronounced against intestinal pathogens: dysentery bacilli (e.g., Shigella spp.) and Escherichia coli are prime targets, as the compound disrupts their cell wall integrity, interferes with DNA replication, and inhibits the synthesis of essential proteins, effectively halting their proliferation. This dual mechanism not only kills existing bacteria but also prevents the spread of infection within the gastrointestinal tract.
Anti-arrhythmic Effects: Modulating Cardiac Function at a Cellular Level
- The anti-arrhythmic properties of berberine hydrochloride powder stem from its direct interaction with cardiac tissues, where it exerts precise regulatory effects on myocardial electrophysiology. Studies indicate it acts on ion channels in cardiac cells, particularly by inhibiting excessive sodium and calcium influx while regulating potassium efflux—key processes that stabilize the heart’s electrical activity. This modulation helps normalize abnormal heart rhythms, such as atrial fibrillation, ventricular premature beats, and supraventricular tachycardia, by prolonging the refractory period of cardiac muscle and preventing erratic impulse conduction.
Treatment of Gastrointestinal Diseases: Targeting Root Causes of Mucosal Damage
- Berberine hydrochloride powder’s efficacy in gastrointestinal disorders arises from a synergistic combination of acid-suppressive, mucosal-protective, and regenerative effects. It directly inhibits the secretion of gastric acid by blocking histamine H2 receptors and reducing proton pump activity, thereby lowering gastric juice acidity—a critical factor in preventing further erosion of the gastric and duodenal mucosa in conditions like peptic ulcers.

Berberine hydrochloride Uses
1.Pharmaceutical Field: Dual Roles in Anti-infection and Metabolic Regulation
Coptis root extract powder plays a significant role in the pharmaceutical industry. It has a marked inhibitory effect on pathogenic microorganisms such as bacteria and fungi, making it a commonly used pharmaceutical ingredient in the treatment of intestinal infections (e.g., bacillary dysentery, enteritis). By interfering with the metabolic processes of pathogenic microorganisms, it effectively prevents the reproduction of pathogens and alleviates symptoms like diarrhea and abdominal pain. Meanwhile, recent studies have found that it can also regulate glucose and lipid metabolism, helping to improve blood sugar levels in patients with type 2 diabetes. It enhances insulin sensitivity by activating the AMPK signaling pathway, becoming a potential option for the auxiliary treatment of metabolic diseases.
2. Health Product Industry: A Natural Boost for Intestinal Health and Immune Regulation
In the health product sector, Coptis root extract powder is often made into capsules or tablets and used as an intestinal microecological regulator. It can promote the proliferation of beneficial intestinal bacteria (such as bifidobacteria), inhibit the excessive growth of harmful bacteria, maintain the balance of intestinal flora, and thereby improve digestive function. In addition, it has a certain immune-enhancing effect, which can stimulate the activity of immune cells and enhance the body's resistance. It is especially suitable for people with weak intestinal function or low immunity as a daily health supplement.

3. Veterinary Medicine Field: A Powerful Tool for the Prevention and Treatment of Infectious Diseases in Livestock and Poultry
Coptis root extract powder is mostly used in veterinary medicine to prevent and treat intestinal infectious diseases in livestock and poultry, such as pullorum disease in chickens and colibacillosis in pigs. Compared with some chemical antibiotics, it is less likely to produce drug resistance and can reduce drug residues in animals, conforming to the development trend of green breeding. At the same time, in aquaculture, it can be used to prevent and treat bacterial enteritis, gill rot disease, etc. in fish, improving the survival rate of aquaculture.
4. Cosmetics Field: A Natural Ingredient with Anti-inflammatory and Antioxidant Properties
With the popularity of natural ingredients in cosmetics, berberine hydrochloride powder has gradually attracted attention due to its anti-inflammatory and antioxidant properties. In skin care products, it can inhibit Propionibacterium acnes.
5. Scientific Research Field: A Valuable Tool for Mechanism Exploration
Coptis root extract powder is also widely used in scientific research. It serves as an important research tool in studies related to microbiology, pharmacology, and metabolomics. Researchers use it to explore the interaction mechanisms between drugs and microorganisms, the regulatory pathways of metabolic diseases, etc., providing a basis for the development of new drugs and the improvement of existing treatment schemes. Its clear chemical structure and relatively definite biological activity make it a commonly used substance in laboratory studies.

Why choose KINTAI Berberine Hydrochloride?
- Premium Natural Sourcing:Healthkintai® Coptis root extract Powder starts with meticulous selection of raw materials, sourced exclusively from organically cultivated Coptis chinensis rhizomes in ecologically pristine regions.
- Science-Backed Formulation:At the core of Healthkintai®’s advantage lies its integration of traditional knowledge with modern scientific rigor. The powder undergoes triple-layer quality testing: first, phytochemical screening to verify alkaloid profile; second, microbial load assessment to ensure sterility; and third, stability testing under varying temperature and humidity conditions.
- Versatile Application:Healthkintai® Coptis root extract Powder stands out for its seamless integration into multiple product categories, reflecting the brand’s understanding of varied market needs. In pharmaceuticals, it serves as an active ingredient in anti-diarrheal and anti-inflammatory formulations, leveraging its broad-spectrum antibacterial action.
FAQ
Q1: What is berberine hydrochloride used for?
A1:Berberine Hydrochloride belongs to the class of alkaloids or herbal supplements. It plays a key role in blood sugar (glucose) metabolism and cardiovascular health.
Q2:Is berberine hydrochloride the same as berberine?
A1:Berberine and Berberine hydrochloride (HCL) or HCl) are not the same. Berberine is a yellow-colored alkaloid found in certain plants as noted above. However, Berberine HCL is crude berberine which has been chemically altered to become an alkaloidal salt.
KINTAI Certifications

Send Inquiry

_1758091668469.jpg)